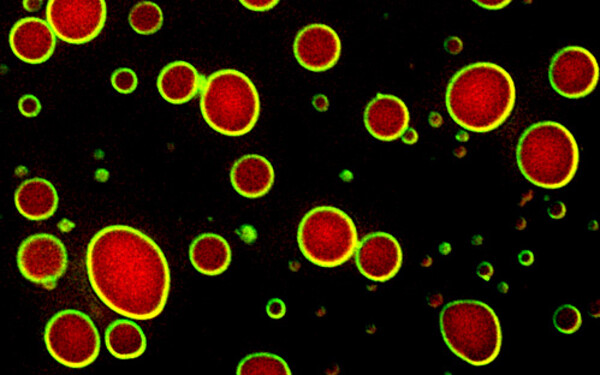

Spotlights
Nuclear pore basket filaments unveiled
The nuclear pore basket is positioned on the nucleoplasmic side of the nuclear pore complex (NPC). Although it plays crucial roles in nucleocytoplasmic transport, its molecular architecture has remained unclear. In a recent study (Stankunas & Köhler, Nature Cell Biology, 2024), we identified key structural features of the basket filaments and their attachment to the NPC's main body. By combining electron microscopy, membrane-templated protein reconstitution in vitro, and cellular validation, our study reveals how NPCs assemble the basket, anchor it to both the nuclear envelope membrane and a specific docking site on the NPC core, and endow it with remarkable structural plasticity.
Lipid chemistry empowers nuclear shape
The cell nucleus is surrounded by a spherical double membrane called the nuclear envelope. An intriguing question was how this envelope can be elastic enough to accommodate shape changes that cells experience as they move through tissues, but also rigid enough to maintain nuclear integrity. We discovered that the chemistry of membrane lipids is key for this versatility (Romanauska & Köhler, Nature Cell Biology, 2023). When this chemistry is perturbed, the nuclear membranes become stiff and prone to rupture, and nuclei lose their typical round shape and morph into a polyhedron.
Building a nuclear pore basket scaffold
The nuclear pore basket is a conical, net-like structure that is attached to the main body of the nuclear pore complex. The basket has numerous functions in nucleocytoplasmic transport and gene expression. Moreover, when huge cargo is transported through the pore, the basket can expand and then contract again, suggesting a great degree of structural plasticity. Scientists have long tried to understand how the nuclear basket can achieve this, but its biochemical fragility prohibited a reconstitution from purified components . We have now managed to reconstitute key parts of the basket on synthetic membranes. (Cibulka, et. al., Science Advances). Our study reveals an intricate assembly principle, characterized by a flexible 'suspension cable’ that ties the basket together, and opens avenues to reconstitute the early stages of nuclear pore biogenesis.
How to detox the nucleus of unsaturated fat
Excess unsaturated fat in cells must be detoxified. We recently discovered that cells package toxic unsaturated fatty acids into lipid droplets that form specifically on the outer nuclear membrane and ER (Romanauska & Köhler, Developmental Cell, 2021). By contrast, lipid droplet formation at the inner nuclear membrane is switched off. In doing so, toxic fat is channeled away from the genome-filled nuclear interior. We suggest that this mechanism protects both the functionality of the nuclear envelope membrane and prevents the flooding of the genome with lipid droplets. Intriguingly, pathological accumulation of nuclear lipid droplets in liver cells has been observed in mouse-models of non-alcoholic fatty liver disease (NAFLD). These observations raise many questions about the role of dysregulated nuclear envelope lipid metabolism in obesity and liver disease, and whether such pathways can be pharmacologically reprogrammed.
Layered Liquids – reaction chambers for gene regulation
Throughout all kingdoms of life, cells use compartmentalization to create functionally distinct units in what would otherwise be a chaotic cellular environment. We usually think of these compartments as requiring a lipid bilayer to differentially concentrate certain factors. Recent studies, however, suggest a new type of organelle which is based on a process called liquid–liquid phase separation (LLPS). This process – the same that underlies oil and water demixing - can lead to the formation of fluid-like compartments. The organizing principles of these phase-separated structures are poorly understood and represent a new frontier in biology. We recently discovered layered protein droplets, in which a chromatin-modifying enzyme encapsulates a liquid scaffold (Gallego, Schneider, Mittal et al., Nature 2020). The scaffold attracts chromatin and promotes its modification by ubiquitin. This is an intriguing example of a dynamic nuclear sub-compartment that organizes enzymatic activity in a unique way. Ultimately, our research can generate a new understanding of how cells utilize biochemical ‘liquidity’ as a shaping force for constructing the nucleus - the sophisticated organelle that is central to eukaryotic life.
Lipid Metabolism of the Inner Nuclear Membrane
From a cytoplasmic view, the inner nuclear membrane is the most remote territory of the endoplasmic reticulum (ER), both in distance and difficulty of access. To get there, any lipid or protein must pass through the NPCs. Whereas the ER and outer nuclear membrane are highly active in converting nutrients into building blocks for lipids and membranes, the inner nuclear membrane was thought to be metabolically inactive and to receive its entire lipids from the ER via the NPC route. We recently discovered metabolic turnover of lipids at the inner nuclear membrane of budding yeast, and found that the inner nuclear membrane can form lipid droplets that are used for lipid storage (Romanauska & Köhler, Cell 2018). We identified the genetic circuit for the synthesis of nuclear lipid droplets and showed how these organelles participate in gene regulation. This study opens avenues for exploring how inner nuclear membrane lipids signal to the genome and which role the inner nuclear membrane plays in human metabolic diseases.
Shaping the Nuclear Envelope
The assembly of new NPCs is tightly controlled. NPCs are embedded in holes formed by the fusion of the outer and inner nuclear membranes. Inserting a new NPC into an intact nuclear envelope is a fascinating, but poorly understood mechanical problem. Put simply, a hole must be pierced without the balloon popping. Specifically, the inner and outer nuclear membrane have to be bent and fused to open a pore membrane, which has to be stabilized afterwards. In conjunction with this membrane remodeling event, ∼500 nuclear pore proteins have to assemble into a functional NPC to prevent uncontrolled leakage of nuclear or cytoplasmic material. We have discovered a new function for the NPC basket in shaping the nuclear membrane to promote NPC and nuclear envelope integrity (Mészáros et al., Dev Cell, 2015). Future studies aim at understanding how various NPC proteins cooperate to sculpt their membrane environment. We use biochemical reconstitution as a tool to get key insights into what is minimally needed and how mechanisms emerge from component parts.
Decrypting Cryptobiosis in Tardigrades
Tardigrades (also known as water bears or moss piglets) are one of the most resilient animals on our planet: they withstand conditions that would fatal to nearly all other life forms on earth. This includes temperatures from close to absolute zero to about 150°C, pressures six times greater than those found in the deepest ocean trenches, ionizing radiation at doses lethal for a human, and even the vacuum of outer space. Tardigrades can go without food or water for decades, only to rehydrate, forage, and reproduce. They survive this by falling into an enigmatic state called cryptobiosis (hidden life), in which they are neither dead nor alive. We are investigating selected aspects of Tardigrade biology with the support of the Swiss NOMIS Foundation. We want to understand their outstanding robustness, specifically, how nuclear envelope architecture and function is preserved under extreme conditions.
Nuclear Ubiquitin Signaling
Related to our interest in gene expression, we are studying the modification of chromatin by ubiquitin. When appended to histones, ubiquitin functions as an important epigenetic switch to regulate multiple steps of transcription. Histone H2B monoubiquitination is mediated by the E2 and E3 enzymes Rad6 and Bre1 (Gallego et al., PNAS 2016). Their activity is counteracted by a deubiquitinase of the SAGA complex (Köhler et al., Cell 2010). We are dissecting the structure and function of this intricate molecular machinery to understand its biology in health and disease. Recently, we have begun to study selected aspects of nuclear protein quality control and its links to nuclear envelope homeostasis.

Dea Slade
Dea Slade Gaia Novarino
Gaia Novarino